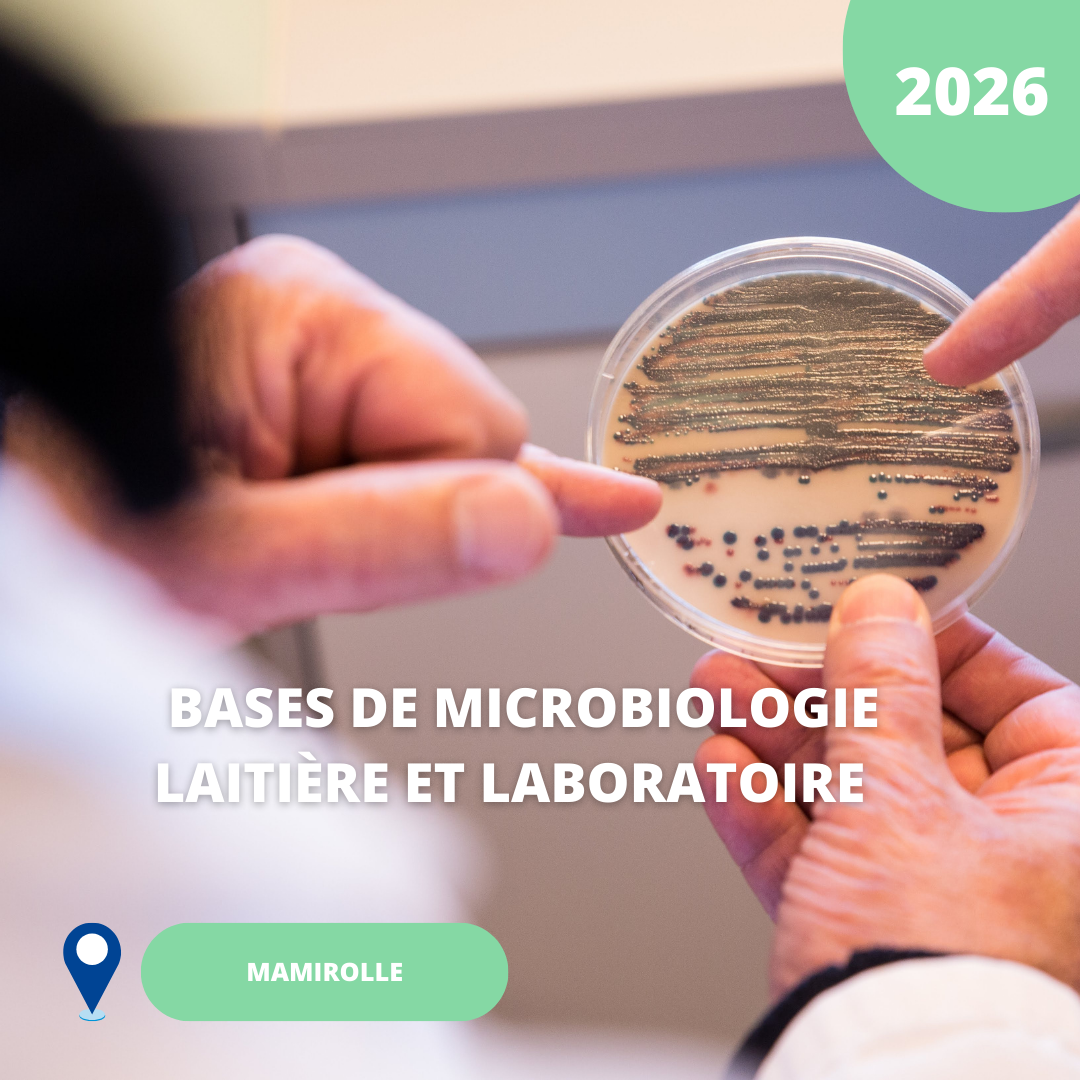

Description du stage
Contenu général :
- Bases de microbologie : cellule, reproduction et facteurs de croissance
- Micro-organismes rencontrés et recherchés dans le lait cru
- Applications pratiques : bonnes pratiques de laboratoire, prélèvement, dénombrement sur milieux liquides et solides, microscopie, lecture
et interprétation résultats
Publics ciblés :
Personnels de production débutant ou services support, porteurs de projet …
Date : S37 – 07/09/2026 (13h30) au 11/09/026 (12h00)
Nous consulter pour toute question relative à une situation de HANDICAP

Avis
Il n’y a pas encore d’avis.